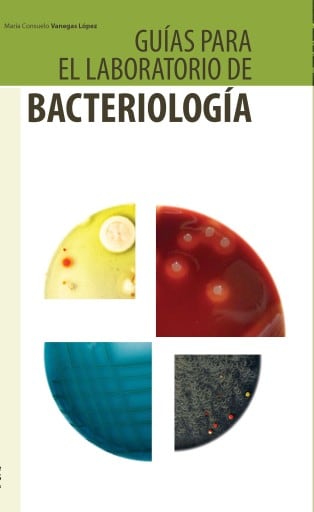
Guías para el laboratorio de bacteriología

Guías para el laboratorio de bacteriología
María Consuelo Vanegas López
Explora las bases de la microbiología con Guías para el laboratorio de bacteriología de María Consuelo Vanegas López. Este libro imprescindible en Ediciones Uniandes te lleva paso a paso por técnicas y metodologías clave para dominar el mundo bacteriano. ¿Listo para profundizar?
Comprar en:
Detalles
ISBN: 9789587741049
Editorial: Ediciones Uniandes
Género: No ficción infantil > Ciencia y naturaleza > Biología, No ficción infantil > Ciencia y naturaleza, Medicina > Enfermedades infecciosas, Medicina, Medicina > Microbiología, No ficción infantil
Fecha de edición: 01-11-2015
Sobre esta publicación
Este libro reúne material esencial para el estudio de las bacterias en el laboratorio. Aborda temas fundamentales como los principios básicos de bioseguridad, las técnicas de microscopia y los protocolos universales para la tinción y visualización de las bacterias con microscopía de la luz electrónica; también enseña al lector los diferentes métodos de siembra y aislamiento de bacterias, además de las reacciones bioquímicas tradicionales más utilizadas para su identificación. Concluye con la presentación de algunas de las técnicas moleculares utilizadas en la actualidad para identificar bacterias, una revisión sobre las que se pueden aislar del agua, del suelo y, en general, del medio ambiente, y los diferentes métodos de conservación. Guías para el laboratorio de bacteriología es una herramienta esencial para la formación de estudiantes y para la capacitación y la actualización de profesionales interesados en los grupos bacterianos de mayor importancia en la industria, la clínica y los estudios ambientales, así como en los investigados en microbiología.
